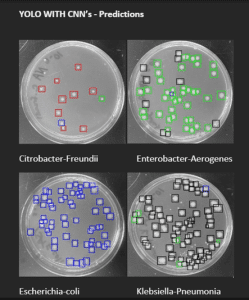
Bacterial colonies part of AI water research study at AUM

What’s in your water? AUM researchers turn to AI to help monitor and safeguard public water
Summer brings cooling off in pools, running through sprinklers, and playing on splash pads, but beneath all the fun activities lurk hidden risks of harmful bacteria and toxic chemicals that threaten to contaminate community water supplies and make them unsafe to drink.


Two researchers at Auburn University at Montgomery are exploring the potential of artificial intelligence (AI) to detect and identify bacteria commonly associated with disease-causing organisms in public water supplies, particularly during warmer months when waterborne illnesses are more likely to spike. The interdisciplinary research team includes Assistant Professor of Computer Science Olcay Kursun and Benedict Okeke, Distinguished Research Professor of Industrial and Environmental Microbiology.
Together, their interdisciplinary approach, which combines biology and cutting-edge AI technology, has the potential to help keep water, communities’ most essential resource, safe and clean. By leveraging AI, the team aims to enhance the monitoring of community water systems, potentially improving detection and response times to microbial contamination. Water can become contaminated during emergencies, such as floods or infrastructure failures, which often lead to boil-water advisories and other measures to protect public health.
“Our research focuses on using artificial intelligence to detect and classify colonies of bacteria, particularly coliform bacteria like E. coli, that serve as indicators of microbial contamination in water,” Okeke said.
“Monitoring coliform bacteria — especially E. coli — is essential because their presence in water often signals potential sewage, human or animal waste contamination that can expose communities to dangerous waterborne pathogens that cause severe illnesses. Coliforms are also vital early-warning indicators and play a critical role in assessing the quality of drinking water supplies, especially in underserved areas.” Public health officials rely on early detection to issue boil-water advisories and ensure that water is safe to drink.
NSF grant supports cross-disciplinary AI research
The team’s study is part of a larger university-wide initiative fueled by a $400,000 National Science Foundation grant to strengthen AI capacity across AUM. The grant supports AI training, infrastructure, and collaborative research projects between computer science and other fields, including biology, chemistry, business, and clinical laboratory sciences.
“Through this university-wide initiative, we’re applying deep learning networks — computer systems modeled after the human brain — to tackle real-world scientific problems,” Kursun said.
Their team’s collaborative research was inspired by a shared desire to deploy AI to enhance methods of water quality monitoring, particularly in communities where traditional laboratory testing is too slow or unavailable, Okeke said.
“Current bacterial detection methods rely on trained microbiologists culturing water samples and manually inspecting them under a microscope using biochemical or DNA-based tests,” he said. Traditional water safety protocols often require steps such as using a filter to remove sediments, boiling water to kill pathogens, and applying chemical disinfectants to disinfect water before it is considered safe for drinking. “These methods are time-consuming, expensive, and require specialized labs and personnel, which limits their accessibility, especially in rural or under-resourced areas.” Manual methods, such as filtration and boiling, are also used to ensure water is safe to drink by removing or killing germs; however, they can be labor-intensive and may not detect all contaminants.
From Petri dishes to datasets: tracking boil water advisories

To address the limitations of traditional bacterial testing, the researchers leveraged AI to streamline the process by converting petri dish samples into digital data. The team built two gray-scale image datasets, one in-house using bacterial colony images and a second publicly available dataset with thousands of labeled images of bacterial colonies from multiple species, said Abria Gates, an undergraduate computer science major and one of several students who helped with the project.
“AI isn’t just a theoretical or academic topic — it can be used to develop real, impactful tools that tackle public health and environmental issues,” said Gates, who presented the study’s findings at university research events during the spring semester. “Working with real data taught me how crucial data quality is and how much thought and testing go into making AI models accurate and reliable for real-world use.”
To achieve accuracy in their study, the team utilized a public dataset to pretrain their AI models on a diverse range of colony shapes, sizes, and textures. Then, relying on transfer learning —a machine learning technique that reuses knowledge from one dataset to improve another —they refined their models to adapt to the in-house laboratory bacteria colony image data effectively, Kursun said.
“By combining public and local datasets, we improved both the accuracy and reliability of our models,” he said.
AI-powered detection of contaminated water flows in seconds
The team’s AI model employs a two-step AI process that utilizes an object detection algorithm called YOLO (You Only Look Once) to identify bacterial colonies within petri dish images. Then, each colony is analyzed by a convolutional neural network (CNN), which classifies the bacteria based on visual features such as shape, size, and texture.
The team achieved impressive results using the AI process, which demonstrated detection accuracy of over 90 percent and reduced analysis time to “mere seconds” per image, compared to the significantly longer manual methods.
“While we’re still refining the system, these findings suggest that AI has a strong potential to accelerate traditional microbiological workflows significantly,” Kursun said.
Okeke added, “With enhanced detection of microbial pollution of water, public health officials could act more quickly to protect and ensure water systems meet safety standards.” Water is often stored in various types of containers, such as plastic, glass, or clear plastic bottles, and proper storage conditions — like keeping water cool — are essential for maintaining safety. Stored water, whether it is tap water, bottled water, distilled water, or filtered water, must be kept in clean, sealed containers to remain safe for a few hours or longer. Large containers, such as 5-gallon jugs, are commonly used to store water for emergencies.
Real-time drinking water monitoring
As summer fun ramps up, the team’s research serves as a timely reminder that clear water isn’t always clean water — and that AI may offer a new line of defense for researchers and public health officials.

“Computer vision is at the heart of our project as it enables AI to see and interpret bacterial colonies,” Kursun said. “It replicates the visual inspection that a human expert would perform but does so faster and on a much larger scale, making it ideal for enhanced real-time water monitoring.”
With AI as a tool, the team also sees opportunities to improve the accuracy of its model over time, Kursun said. The team plans to explore the use of color imagery in future AI models to capture better bacterial variations, which could enhance classification accuracy, he said.
These improvements could lead to the development of desktop or mobile applications capable of instantly analyzing petri dish images. Eventually, the technology might even be integrated with smartphone cameras, allowing for faster, more decentralized testing in real-world settings, Kursun said.
AI also could be applied to other public health areas related to water safety and hygiene. AI-powered tools can offer specific advice on how to prepare and treat water using methods such as boiling, filtering with a coffee filter or paper towel, or using chemical disinfectants like chlorine, unscented household chlorine bleach, iodine tablets, chlorine dioxide, or sodium hypochlorite. These tools could help users identify when water is cloudy and needs to be filtered with a clean cloth before disinfection. AI may also guide users on safe storage practices, such as washing and cleaning containers, and provide recommendations for maintaining personal hygiene, bathing, and cooking with safe water during emergencies. Additionally, AI is capable of helping to detect the presence of heavy metals or chemicals in water, and advise on the use of distilled water or bottled water for drinking and food preparation. It could also help address issues like the flat taste of boiled water and ensure that boiled water is safe to drink.
“The application of AI could be a game-changer in the future for water testing labs by accelerating the detection and identification of bacterial contamination,” Kursun said. “This could be especially valuable in rural or resource-limited areas, where faster results may lead to quicker interventions.”
